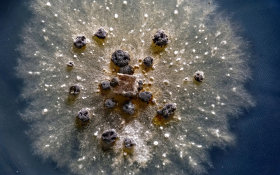

대지를 감싼 짙은 물안개가 아침 햇살에 밀려 서서히 걷히자 소나무 숲속을 하얗게 수놓은 구절초 군락이 모습을 드러냈다. 국화과의 여러해살이 풀로 전국 산과 들에 자생하는 대표적인 가을꽃이다. 음력 9월 9일에 채집해 쓰면 약성이 가장 좋다 하여 이름이 구절초가 되었다고도 한다. 사진은 전북 정읍시 산내면 구절초지방정원에서 진행된 구절초 꽃축제 마지막 날인 지난 13일 모습이다. 원래 구절초는 9~10월에 만개하는데, 13일 기준 개화율이 40%에 불과해 올해는 ‘꽃 없는 꽃 축제’로 막을 내렸다. 안개 자욱한 솔숲 아래 윤슬처럼 반짝이는 구절초 군락을 기대하고 왔다가 빈손으로 되돌아간 아마추어 사진작가가 숱하다. 올해 이곳 구절초는 지금부터 10월 말까지 절정을 이룰 전망이다. 기후변화가 전국의 가을 축제에도 영향을 미치고 있다. 전남 신안 반월박지도의 ‘아스타꽃축제’는 개화 상태가 좋지 않아 취소됐고, 경북 봉화 ‘송이축제’는 버섯이 피지 않아 ‘송이채취’ 체험이 ‘호두채취’ 체험으로 대체됐다. 2024.10.13. 최기웅 기자
- - FileName :
- 피처자연최기웅 (1).jpeg
- - FileSize :
- 19077825 bytes
- - mimeType :
- image/jpeg
- - imageDescription :
- 대지를 감싼 짙은 물안개가 아침 햇살에 밀려 서서히 걷히자 소나무 숲속을 하얗게 수놓은 구절초 군락이 모습을 드러냈다. 국화과의 여러해살이 풀로 전국 산과 들에 자생하는 대표적인 가을꽃이다. 음력 9월 9일에 채집해 쓰면 약성이 가장 좋다 하여 이름이 구절초가 되었다고도 한다. 사진은 전북 정읍시 산내면 구절초지방정원에서 진행된 구절초 꽃축제 마지막 날인 지난 13일 모습이다. 원래 구절초는 9~10월에 만개하는데, 13일 기준 개화율이 40%에 불과해 올해는 ‘꽃 없는 꽃 축제’로 막을 내렸다. 안개 자욱한 솔숲 아래 윤슬처럼 반짝이는 구절초 군락을 기대하고 왔다가 빈손으로 되돌아간 아마추어 사진작가가 숱하다. 올해 이곳 구절초는 지금부터 10월 말까지 절정을 이룰 전망이다. 기후변화가 전국의 가을 축제에도 영향을 미치고 있다. 전남 신안 반월박지도의 ‘아스타꽃축제’는 개화 상태가 좋지 않아 취소됐고, 경북 봉화 ‘송이축제’는 버섯이 피지 않아 ‘송이채취’ 체험이 ‘호두채취’ 체험으로 대체됐다. 2024.10.13. 최기웅 기자
- - Make :
- Canon
- - Model :
- Canon EOS R3
- - XResolution :
- 300/1
- - YResolution :
- 300/1
- - DateTime :
- 2024:10:13 23:56:44
- - ExposureTime :
- 1/100
- - FNumber :
- 22/1
- - ISOSpeedRatings :
- 1000
경북 경주시 안강읍 옥산서원 인근의 나무 둥지에서 호반새가 먹이를 공급하고 있다. 몸 전체가 붉은색을 띤 이 새는 세계자연보전연맹이 정한 멸종위기등급 관심대상 동물이다. 2024.06.25. 최기웅 기자
- - FileName :
- 피처자연최기웅 (1).jpg
- - FileSize :
- 7083639 bytes
- - mimeType :
- image/jpeg
- - imageDescription :
- 경북 경주시 안강읍 옥산서원 인근의 나무 둥지에서 호반새가 먹이를 공급하고 있다. 몸 전체가 붉은색을 띤 이 새는 세계자연보전연맹이 정한 멸종위기등급 관심대상 동물이다. 2024.06.25. 최기웅 기자
- - Make :
- Canon
- - Model :
- Canon EOS R3
- - XResolution :
- 3000000/10000
- - YResolution :
- 3000000/10000
- - DateTime :
- 2024:11:28 15:17:42
- - ExposureTime :
- 1/1000
- - FNumber :
- 4/1
- - ISOSpeedRatings :
- 4000
아기 새가 생애 첫 비행을 위해 둥지 위에 올라섰다. 그 모습을 응원하듯 아빠 새가 먹이를 물어다 주고 있다. 전라북도 군산의 한 야산에 둥지를 틀고 번식에 성공한 긴꼬리딱새의 이소(離巢) 현장이다. 삼광조로도 불리는데 파란색 안경을 쓴 것 같은 독특한 모습이 특징이다. 수컷 성조는 길고 우아한 꼬리 깃털을 가지고 있는데, 몸길이의 약 두 배에 달한다. 여름 철새로 5월에서 7월 사이 일본과 우리나라 제주도 및 남부지방에서 번식한 뒤 중국 남부와 동남아시아 등지에서 겨울을 난다. 국제자연보전연맹(IUCN)이 적색목록 취약종(VU)으로 분류하고, 우리나라도 멸종위기야생생물 2급으로 지정해 보호하고 있다. 아기 새는 둥지 부근에서 비행 연습을 하다 독립하는데, 부모 새는 아기 새 주변을 떠나지 않고 이소를 돕는다. 다 자라 집을 떠나는 자식에게 마지막 한 끼를 챙겨주려는 부모 마음은 새나 인간이나 똑같은 듯하다. 2024.06.26. 중앙일보 최기웅 기자.
- - FileName :
- 피처자연최기웅 (2).jpg
- - FileSize :
- 4564791 bytes
- - mimeType :
- image/jpeg
- - imageDescription :
- 아기 새가 생애 첫 비행을 위해 둥지 위에 올라섰다. 그 모습을 응원하듯 아빠 새가 먹이를 물어다 주고 있다. 전라북도 군산의 한 야산에 둥지를 틀고 번식에 성공한 긴꼬리딱새의 이소(離巢) 현장이다. 삼광조로도 불리는데 파란색 안경을 쓴 것 같은 독특한 모습이 특징이다. 수컷 성조는 길고 우아한 꼬리 깃털을 가지고 있는데, 몸길이의 약 두 배에 달한다. 여름 철새로 5월에서 7월 사이 일본과 우리나라 제주도 및 남부지방에서 번식한 뒤 중국 남부와 동남아시아 등지에서 겨울을 난다. 국제자연보전연맹(IUCN)이 적색목록 취약종(VU)으로 분류하고, 우리나라도 멸종위기야생생물 2급으로 지정해 보호하고 있다. 아기 새는 둥지 부근에서 비행 연습을 하다 독립하는데, 부모 새는 아기 새 주변을 떠나지 않고 이소를 돕는다. 다 자라 집을 떠나는 자식에게 마지막 한 끼를 챙겨주려는 부모 마음은 새나 인간이나 똑같은 듯하다. 2024.06.26. 중앙일보 최기웅 기자.
- - Make :
- Canon
- - Model :
- Canon EOS R3
- - XResolution :
- 3000000/10000
- - YResolution :
- 3000000/10000
- - DateTime :
- 2024:11:28 15:17:31
- - ExposureTime :
- 1/400
- - FNumber :
- 4/1
- - ISOSpeedRatings :
- 2000
샛노란 산수유꽃이 한밤중에도 부지런히 봉우리를 터뜨리며 아름다운 모습을 뽐내고 있다. 겨우내 무채색이던 전남 구례군 산동면 일대가 꽃망울을 터트리기 시작한 산수유 덕에 생긋한 봄의 기운으로 꿈틀대고 있다. 지난겨울 포근한 날씨 탓에 산수유도 올해는 평년보다 일주일 정도 일찍 개화를 시작했다. 다시금 평년 기온을 되찾으며 개화 속도가 주춤하긴 했지만 오는 9일 시작하는 구례산수유꽃축제를 제대로 즐기려면 조금 서두르는 편이 낫겠다. 산동면 계척마을에는 ‘할머니 나무’로 불리는 수령이 1000년 된 산수유나무가 있는데, 1000여 년 전 중국 산둥 지방 처녀가 시집올 때 가져와 심은 산수유가 퍼져 지금의 군락이 됐다는 이야기가 전해져 내려온다. 2024.02.27. 중앙일보 최기웅 기자
- - FileName :
- 피처자연최기웅 (3).jpg
- - FileSize :
- 11425722 bytes
- - mimeType :
- image/jpeg
- - imageDescription :
- 샛노란 산수유꽃이 한밤중에도 부지런히 봉우리를 터뜨리며 아름다운 모습을 뽐내고 있다. 겨우내 무채색이던 전남 구례군 산동면 일대가 꽃망울을 터트리기 시작한 산수유 덕에 생긋한 봄의 기운으로 꿈틀대고 있다. 지난겨울 포근한 날씨 탓에 산수유도 올해는 평년보다 일주일 정도 일찍 개화를 시작했다. 다시금 평년 기온을 되찾으며 개화 속도가 주춤하긴 했지만 오는 9일 시작하는 구례산수유꽃축제를 제대로 즐기려면 조금 서두르는 편이 낫겠다. 산동면 계척마을에는 ‘할머니 나무’로 불리는 수령이 1000년 된 산수유나무가 있는데, 1000여 년 전 중국 산둥 지방 처녀가 시집올 때 가져와 심은 산수유가 퍼져 지금의 군락이 됐다는 이야기가 전해져 내려온다. 2024.02.27. 중앙일보 최기웅 기자
- - Make :
- Canon
- - Model :
- Canon EOS R3
- - XResolution :
- 3000000/10000
- - YResolution :
- 3000000/10000
- - DateTime :
- 2024:02:29 11:12:26
- - ExposureTime :
- 1/6
- - FNumber :
- 32/1
- - ISOSpeedRatings :
- 1000
밤하늘에는 끝없이 은하수가 펼쳐있고, 바다에는 파랗게 반짝이며 일렁이는 파도가 오로라를 연상시킨다. 충남 서천 월하리의 해변이 만조시간이 가까워지자 푸른 빛으로 물들었다. 학명은 Noctiluca scintillans, 한국에서 야광충이라고 불리는 해양 플랑크톤 때문이다. 야광충은 물리적인 자극을 받으면 푸른 빛을 내는데 반딧불이와 같이 루시페린을 통한 생체 발광이다. 밤에는 아름답기만 한 야광충은 낮에는 그리 반갑지 않은 손님이다. 이상 증식을 하게 된다면 적조현상을 일으켜 수산업에 타격을 주기 때문이다. 충남수산자원연구소 측은 “야광충 출현은 지구온난화에 따른 현상이다. 야광충 자체는 해가 없기 때문에 현재 방제 계획은 없지만 증식 상황을 주시하고 있다"고 전했다. 2024.05.11. 중앙일보 최기웅 기자
- - FileName :
- 피처자연최기웅 (4).jpg
- - FileSize :
- 28253178 bytes
- - mimeType :
- image/jpeg
- - imageDescription :
- 밤하늘에는 끝없이 은하수가 펼쳐있고, 바다에는 파랗게 반짝이며 일렁이는 파도가 오로라를 연상시킨다. 충남 서천 월하리의 해변이 만조시간이 가까워지자 푸른 빛으로 물들었다. 학명은 Noctiluca scintillans, 한국에서 야광충이라고 불리는 해양 플랑크톤 때문이다. 야광충은 물리적인 자극을 받으면 푸른 빛을 내는데 반딧불이와 같이 루시페린을 통한 생체 발광이다. 밤에는 아름답기만 한 야광충은 낮에는 그리 반갑지 않은 손님이다. 이상 증식을 하게 된다면 적조현상을 일으켜 수산업에 타격을 주기 때문이다. 충남수산자원연구소 측은 “야광충 출현은 지구온난화에 따른 현상이다. 야광충 자체는 해가 없기 때문에 현재 방제 계획은 없지만 증식 상황을 주시하고 있다"고 전했다. 2024.05.11. 중앙일보 최기웅 기자
- - Make :
- Canon
- - Model :
- Canon EOS R3
- - XResolution :
- 3000000/10000
- - YResolution :
- 3000000/10000
- - DateTime :
- 2024:05:13 11:01:00
- - ExposureTime :
- 10/1
- - FNumber :
- 28/10
- - ISOSpeedRatings :
- 1600
지름 9㎝의 배양접시 위에서 버섯 신종 후보종 균사체가 실처럼 뻗은 덩굴 망 모습으로 자라고 있다. 검은 덩어리들은 균사체가 형성한 균핵이다. 버섯은 생애 대부분을 땅속에서 균사체로 보낸다. 우리가 알고 있는 모습의 ‘버섯’은 식물의 꽃에 해당하는 버섯의 생식기관 자실체다. 균사체가 적절한 온·습도를 접하면 균핵·자실체를 형성하고 포자를 뿌려 번식한다. 버섯은 식물도 동물도 아닌 균류에 속하는 미생물이다. 생태계에서 식물이 생산자, 동물이 소비자라면 균류는 분해자 또는 환원자다. 유기물을 분해해 무기물로 환원한다. 자칫 동·식물 사체와 배설물이 쌓여 쓰레기장이 될 수도 있는 숲을 지키는 ‘자연의 청소부’인 셈이다. 광릉숲에서 균류를 연구하는 국립수목원 한상국 연구관은 “지구 위 100만여 종의 균류 중 90%는 규명되지 않은 상태”라며 “현재 활용 분야에 비해 미지의 영역이 무궁무진하다”고 말했다. 2024.06.04. 최기웅 기자
- - FileName :
- 피처자연최기웅 (5).jpg
- - FileSize :
- 13727679 bytes
- - mimeType :
- image/jpeg
- - imageDescription :
- 지름 9㎝의 배양접시 위에서 버섯 신종 후보종 균사체가 실처럼 뻗은 덩굴 망 모습으로 자라고 있다. 검은 덩어리들은 균사체가 형성한 균핵이다. 버섯은 생애 대부분을 땅속에서 균사체로 보낸다. 우리가 알고 있는 모습의 ‘버섯’은 식물의 꽃에 해당하는 버섯의 생식기관 자실체다. 균사체가 적절한 온·습도를 접하면 균핵·자실체를 형성하고 포자를 뿌려 번식한다. 버섯은 식물도 동물도 아닌 균류에 속하는 미생물이다. 생태계에서 식물이 생산자, 동물이 소비자라면 균류는 분해자 또는 환원자다. 유기물을 분해해 무기물로 환원한다. 자칫 동·식물 사체와 배설물이 쌓여 쓰레기장이 될 수도 있는 숲을 지키는 ‘자연의 청소부’인 셈이다. 광릉숲에서 균류를 연구하는 국립수목원 한상국 연구관은 “지구 위 100만여 종의 균류 중 90%는 규명되지 않은 상태”라며 “현재 활용 분야에 비해 미지의 영역이 무궁무진하다”고 말했다. 2024.06.04. 최기웅 기자
- - Make :
- Canon
- - Model :
- Canon EOS R3
- - XResolution :
- 720000/10000
- - YResolution :
- 720000/10000
- - DateTime :
- 2024:06:12 14:29:44
- - ExposureTime :
- 1/125
- - FNumber :
- 71/10
- - ISOSpeedRatings :
- 400
- - FileName :
- 피처자연최기웅 (6).jpg
- - FileSize :
- 11527716 bytes
- - mimeType :
- image/jpeg
- - imageDescription :
- 강원도 인제군 남면 '비밀의 정원'에 하얗게 서리가 내려 겨울풍경이 되었다. 2024.11.18. 중앙일보 최기웅 기자
- - Make :
- Canon
- - Model :
- Canon EOS R3
- - XResolution :
- 3000000/10000
- - YResolution :
- 3000000/10000
- - DateTime :
- 2024:11:20 10:08:47
- - ExposureTime :
- 1/4
- - FNumber :
- 4/1
- - ISOSpeedRatings :
- 100
독한 더위에도 맥문동이 보랏빛 꽃망울을 터트렸다. 이른 아침 탐방객들이 소나무숲 아래 양탄자처럼 깔린 맥문동 꽃길을 따라 산책에 나섰다. 충남 서천군 장항읍에 위치한 송림산림욕장에 600만 본의 맥문동을 심어 조성한 전국 최대의 맥문동 군락지 모습이다. 푸른 바다와 울창한 소나무숲 그리고 맥문동꽃이 어우러진 풍경 덕분에 이곳은 연간 100만 명이 찾는 관광명소가 됐다. 부산에서 온 남정희(여·75)씨는 “더위 탓인지 꽃 개화 상태가 예년만 못해 조금은 아쉽지만 그래도 소나무가 만들어준 그늘과 꽃향기를 맡으며 더위를 피할 수 있어 좋은 것 같다”고 미소 지었다. 2024.08.22. 중앙일보 최기웅 기자
- - FileName :
- 피처자연최기웅 (7).jpg
- - FileSize :
- 13885809 bytes
- - mimeType :
- image/jpeg
- - imageDescription :
- 독한 더위에도 맥문동이 보랏빛 꽃망울을 터트렸다. 이른 아침 탐방객들이 소나무숲 아래 양탄자처럼 깔린 맥문동 꽃길을 따라 산책에 나섰다. 충남 서천군 장항읍에 위치한 송림산림욕장에 600만 본의 맥문동을 심어 조성한 전국 최대의 맥문동 군락지 모습이다. 푸른 바다와 울창한 소나무숲 그리고 맥문동꽃이 어우러진 풍경 덕분에 이곳은 연간 100만 명이 찾는 관광명소가 됐다. 부산에서 온 남정희(여·75)씨는 “더위 탓인지 꽃 개화 상태가 예년만 못해 조금은 아쉽지만 그래도 소나무가 만들어준 그늘과 꽃향기를 맡으며 더위를 피할 수 있어 좋은 것 같다”고 미소 지었다. 2024.08.22. 중앙일보 최기웅 기자
- - Make :
- Canon
- - Model :
- Canon EOS R3
- - XResolution :
- 3000000/10000
- - YResolution :
- 3000000/10000
- - DateTime :
- 2024:08:22 14:32:20
- - ExposureTime :
- 1/250
- - FNumber :
- 56/10
- - ISOSpeedRatings :
- 1600